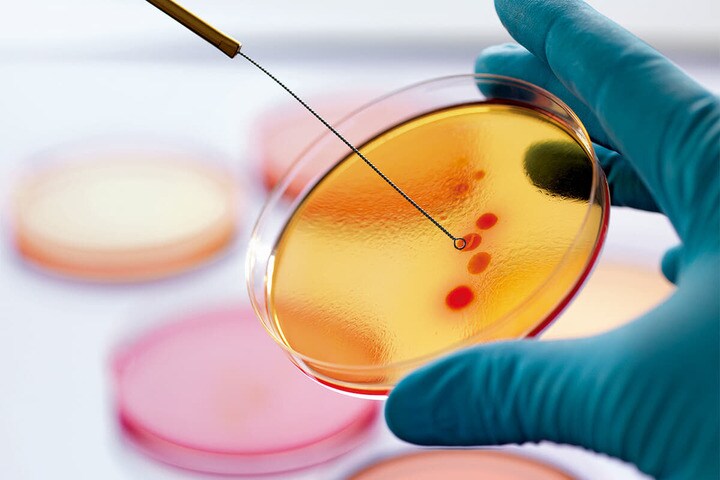
231212P62_KSB_01.jpg

毎年1000万の死者が
東南アジアおよび太平洋地域の11カ国を対象にした今回の調査では、抗生物質「セフトリアキソン」が、今では新生児の敗血症や髄膜炎の治療において3例に1例でしか有効でないことが判明した。別の抗生物質「ゲンタマイシン」も、新生児の敗血症の2例に1例でしか効果が認められなかったという。
薬剤耐性の問題は、高度な医療技術を使えない東南アジアや太平洋地域の諸国だけではなく、アメリカやその他の地域でもますます大きな問題になりつつある。
ハドソンは「臨床的に使用可能な(つまり安全性の確認されている)抗生物質に耐性を持つ細菌に感染している患者は現在でも約280万人に上り、このうちアメリカでは3万5000人、世界全体では70万人が死亡している」と指摘。「しかるべき対策を取らなければ、2050年の時点で毎年1000万の死者が出るだろうとWHOは警告している」と述べた。
今回の論文は、薬剤耐性の問題は子供にとって特に深刻だと指摘している。新たな抗生物質の開発に当たって小児が臨床試験の対象になる例は少なく、小児への投与が認可される可能性も低いからだ。
豪シドニー大学公衆衛生大学院の感染症専門家で、論文の筆頭著者でもあるフィービー・ウィリアムズはメディア向けの声明で、「抗生物質に関する臨床研究の焦点は成人に向けられており、あまりに多くの場合、小児や新生児は置き去りにされている。だから新たな治療法を開発しようにも手段やデータが非常に乏しい」としている。
この状況を改善するには、新薬の開発にさらなる投資を行う必要がある。「アメリカでは世界の他のどの国よりも、製薬会社が抗生物質に高い価格を設定できる。だから患者にとっても医師にとっても、それだけ選択肢が多いと言える。しかし、それでも新薬の開発には莫大な金がかかる」とバローズは言う。
さらにバローズによれば、ほとんどの製薬会社は「もう新しい抗生物質の開発に関心を持っていない」。数日、あるいは数週間で症状が治まる感染症よりも、「慢性的な症状を治療するために長期の投与が必要になる薬剤のほうが儲かる」からだ。
耐性菌が増えている今の時代に、これは大きな問題だ。バローズは言う。「今でさえ(強力だが副作用も強い)『最後の砦』の薬剤を使わざるを得ない。この最後の砦が破られたら、もう打つ手はない」

偽情報があふれる時代。医療・健康の知識を正しく見極め理解する最適の方法は?















